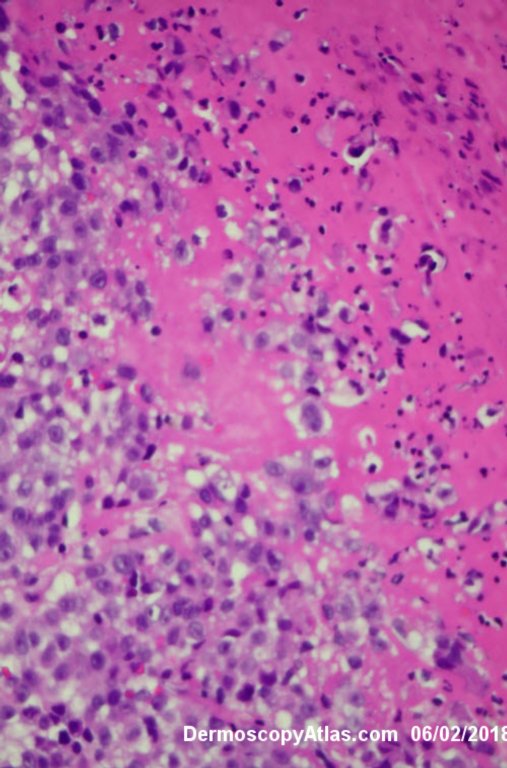

Site: Leg
Diagnosis: Melanoma invasive
Sex: F
Age: 84
Type: Dermlite Polarised
Submitted By: Ian McColl
Description: Multiple colours in this pigmented lesion on the lower leg. New pink area
History:
Lady in her early 80s who presented with this lesion on her ankle. The pigmented area had been there for some time but the pink area was bleeding and new. Shave of surrounding area and a punch biopsy of the new pink area showed mainly surrounding in situ melanoma with invasive melanoma in the pink area 1.8 mm thick. Having a 2cms margin excision of the whole area and a graft.